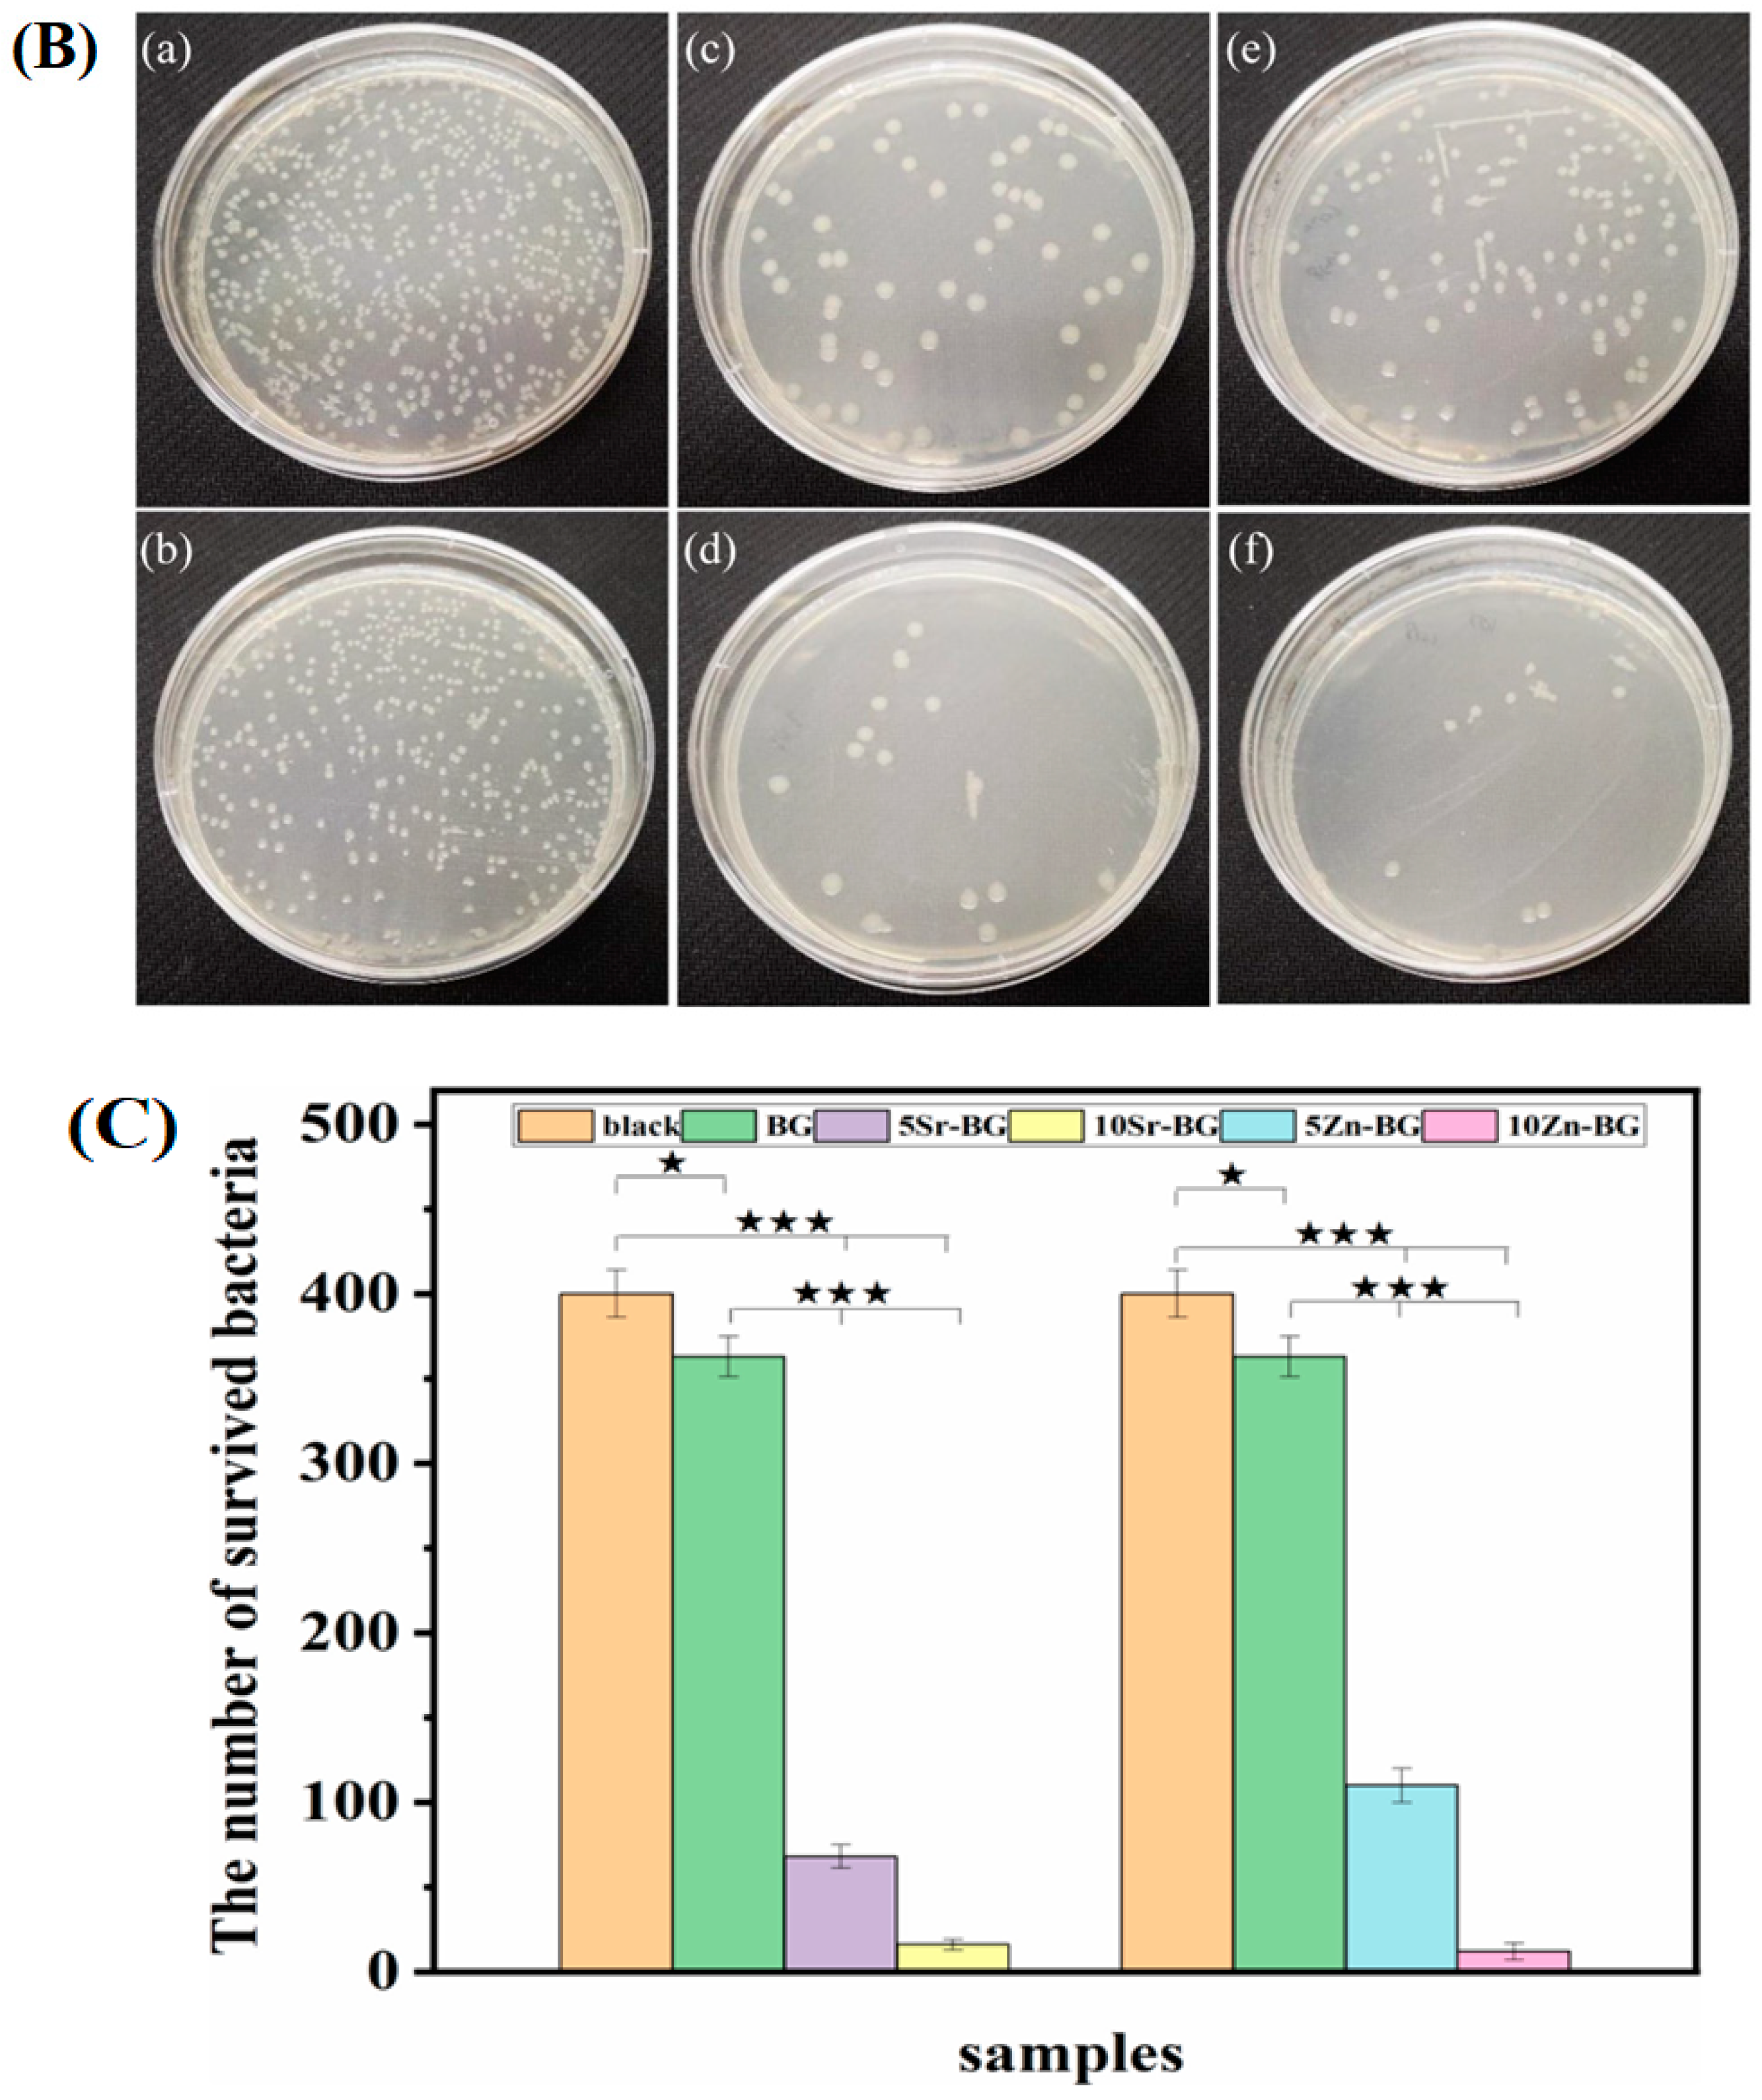
Jfb 15 00258 g004b

Advances in Zinc-Containing Bioactive Glasses: A Comprehensive Review
Abstract
1. Introduction
2. Synthesis of Zinc-Doped BGs
2.1. Melt-Quenching
- The process of shaping through casting in molds, rapid cooling in water, or drawing into continuous fibers.
- Heating the glass above its glass transition temperature (Tg) enables the particles to sinter, forming a porous scaffold, allowing for the drawing of fibers from a pre-form, or facilitating the sealing of particles to create coatings on a surface [52].
2.2. Sol-Gel
3. Physico-Mechanical Properties of ZBGs
4. Biological Roles of ZBGs
4.1. Antibacterial Activity
4.2. Osteogenesis

4.3. Angiogenesis
4.4. Anti-Inflammatory
4.5. Cytotoxicity
5. Biomedical Applications of ZBGs
5.1. Bone Tissue Scaffolds
5.2. Bone Regeneration and Wound Healing
5.3. Coatings of Orthopedic Implant
5.4. Bone Grafts and Filling Materials
| BG Composition | Zinc Content | Method | Applications | Medical Device Form | Main Results | Ref. |
|---|---|---|---|---|---|---|
| Zn-doped 45S5-derived systems | 5, 20 mol% | Melt-quenching | Tissue repair | Powder |
| [126] |
| xZnO–(57.0 − x)CaO–35.4SiO2–7.2P2O5–0.4CaF2 in mol% | 0–14.2 mol% | Melt-quenching | Bone formation | Powder |
| [161] |
| SrO–ZnO–SiO2 | 0.32 (mol fraction) | Melt-quenching | Bone graft | Granule |
| [158] |
| Na2O–K2O–MgO–Cao–P2O5–B2O3–TiO2–SiO2–ZnO | 0–5 mol% | Melt-spinning | Bone tissue engineering | Scaffold |
| [125] |
| SiO2–CaO–P2O5–ZnO | 1, 3, 5 mol% | Sol-gel | Bone integration | powder |
| [162] |
| SiO2–ZnO–CaO–SrO–Na2O | 0.2–0 mole (fraction) | Melt-quenching | Osseous integration | Scaffold |
| [163] |
| SiO2–CaO– P2O5–ZnO | 0, 4, 7 mol% | Evaporation-induced self-assembly | Bone regeneration | Scaffold |
| [127] |
| SiO2–Na2O–ZnO–CaO–MgO–P2O5 | 1.24 and 2.4 mol% | Melt-quenching | Wound healing Orthopedic infections | Scaffold |
| [164] |
| ZnO–Na2O–SiO2–CaO–P2O5–MgO | 6, 8, 10 mol% | Sol-gel | Bone regeneration | Powder |
| [165] |
| SiO2–CaO–ZnO | 2 and 5 mol% | Sol-gel | Odontogenic and angiogenic | Powder |
| [116] |
| B2O3–MgO–SiO2–Na2O–CaO–P2O5–ZnO | 2 mol% | Sol-gel | Bone regeneration | Powder |
| [166] |
| 49CaO–5ZnO–6P2O5–40SiO2 | 5 mol% | Sol-gel and electrospinning | Nasal tissues treatment | Scaffold |
| [141] |
| 70SiO2–25CaO–5ZnO | 8 mol% | Microemulsion assisted sol-gel | Bone regeneration Wound healing | Powders |
| [43] |
| (I) ZnO–SiO2–P2O5–CaO (II) Ag2O–SiO2–P2O5–CaO | 2 and 4 mol% | Sol-gel | Bone tissue | Powder |
| [93] |
| 80SiO2–15CaO–5P2O5–4ZnO | 4 mol% | Evaporation induced self-assembly | Bone infection | Scaffold |
| [167] |
| xZnO–22Na2O–24CaO–(54 − x)–P2O5 | 2, 4, 6, 8, 10 mol% | Melt-quenching | Bone implant | Powder |
| [80] |
| 60SiO2–(36 − x)CaO–4P2O5–xZnO | 1, 5 mol% | Sol-gel | Bone substitute An additive in toothpaste | Powder |
| [168] |
| 60SiO2–4P2O5–31CaO–xSrO– (5 − x)ZnO | 1–5 mol% | Sol-gel | Bone substitute | Powder |
| [169] |
| SiO2 –CaO–P2O5–ZnO | 1, 3, 5 mol% | Evaporation induced self-assembly | Coating materials | Scaffold |
| [154] |
6. Conclusions and Future Perspectives
Author Contributions
Funding
Data Availability Statement
Conflicts of Interest
References
- Shearer, A.; Montazerian, M.; Mauro, J.C. Modern definition of bioactive glasses and glass-ceramics. J. Non-Cryst. Solids 2023, 608, 122228. [Google Scholar] [CrossRef]
- Gerhardt, L.C.; Boccaccini, A.R. Bioactive Glass and Glass-Ceramic Scaffolds for Bone Tissue Engineering. Materials 2010, 3, 3867–3910. [Google Scholar] [CrossRef] [PubMed]
- Ege, D.; Zheng, K.; Boccaccini, A.R. Borate bioactive glasses (BBG): Bone regeneration, wound healing applications, and future directions. ACS Appl. Bio Mater. 2022, 5, 3608–3622. [Google Scholar] [CrossRef]
- Zeimaran, E.; Pourshahrestani, S.; Fathi, A.; bin Abd Razak, N.A.; Kadri, N.A.; Sheikhi, A.; Baino, F. Advances in bioactive glass-containing injectable hydrogel biomaterials for tissue regeneration. Acta Biomater. 2021, 136, 1–36. [Google Scholar] [CrossRef] [PubMed]
- Cao, W.; Hench, L.L. Bioactive materials. Ceram. Int. 1996, 22, 493–507. [Google Scholar] [CrossRef]
- Montazerian, M.; Zanotto, E.D. A guided walk through Larry Hench’s monumental discoveries. J. Mater. Sci. 2017, 52, 8695–8732. [Google Scholar] [CrossRef]
- Cannio, M.; Bellucci, D.; Roether, J.A.; Boccaccini, D.N.; Cannillo, V. Bioactive Glass Applications: A Literature Review of Human Clinical Trials. Materials 2021, 14, 5440. [Google Scholar] [CrossRef]
- Sun, W.; Ye, B.; Chen, S.; Zeng, L.; Lu, H.; Wan, Y.; Gao, Q.; Chen, K.; Qu, Y.; Wu, B.; et al. Neuro–bone tissue engineering: Emerging mechanisms, potential strategies, and current challenges. Bone Res. 2023, 11, 65. [Google Scholar] [CrossRef]
- Zamani, Y.; Zareein, A.; Bazli, L.; NasrAzadani, R.; Pasha Mahammod, B.; Nasibi, S.; Modarresi Chahardehi, A. Nanodiamond-containing composites for tissue scaffolds and surgical implants: A review. J. Compos. Compd. 2020, 2, 215–227. [Google Scholar] [CrossRef]
- Daraei, J. Production and characterization of PCL (Polycaprolactone) coated TCP/nanoBG composite scaffolds by sponge foam method for orthopedic applications. J. Compos. Compd. 2020, 2, 44–49. [Google Scholar] [CrossRef]
- Barreto, M.E.V.; Medeiros, R.P.; Shearer, A.; Fook, M.V.L.; Montazerian, M.; Mauro, J.C. Gelatin and Bioactive Glass Composites for Tissue Engineering: A Review. J. Funct. Biomater. 2023, 14, 23. [Google Scholar] [CrossRef]
- Amini, Z.; Rudsary, S.S.; Shahraeini, S.S.; Dizaji, B.F.; Goleij, P.; Bakhtiari, A.; Irani, M.; Sharifianjazi, F. Magnetic bioactive glasses/Cisplatin loaded-chitosan (CS)-grafted-poly (ε-caprolactone) nanofibers against bone cancer treatment. Carbohydr. Polym. 2021, 258, 117680. [Google Scholar] [CrossRef]
- Shearer, A.; Montazerian, M.; Sly, J.J.; Hill, R.G.; Mauro, J.C. Trends and perspectives on the commercialization of bioactive glasses. Acta Biomater. 2023, 160, 14–31. [Google Scholar] [CrossRef]
- Li, S.; Cui, Y.; Liu, H.; Tian, Y.; Wang, G.; Fan, Y.; Wang, J.; Wu, D.; Wang, Y. Application of bioactive metal ions in the treatment of bone defects. J. Mater. Chem. B 2022, 10, 9369–9388. [Google Scholar] [CrossRef]
- Ciosek, Ż.; Kot, K.; Kosik-Bogacka, D.; Łanocha-Arendarczyk, N.; Rotter, I. The Effects of Calcium, Magnesium, Phosphorus, Fluoride, and Lead on Bone Tissue. Biomolecules 2021, 11, 506. [Google Scholar] [CrossRef]
- Ebrahimi, M.; Manafi, S.; Sharifianjazi, F. The effect of Ag2O and MgO dopants on the bioactivity, biocompatibility, and antibacterial properties of 58S bioactive glass synthesized by the sol-gel method. J. Non-Cryst. Solids 2023, 606, 122189. [Google Scholar] [CrossRef]
- Baino, F.; Montazerian, M.; Verné, E. Cobalt-Doped Bioactive Glasses for Biomedical Applications: A Review. Materials 2023, 16, 4994. [Google Scholar] [CrossRef]
- O’Neill, E.; Awale, G.; Daneshmandi, L.; Umerah, O.; Lo, K.W.-H. The roles of ions on bone regeneration. Drug Discov. Today 2018, 23, 879–890. [Google Scholar] [CrossRef]
- Ansari, M. Bone tissue regeneration: Biology, strategies and interface studies. Prog. Biomater. 2019, 8, 223–237. [Google Scholar] [CrossRef]
- Luo, Y.; Liu, H.; Zhang, Y.; Liu, Y.; Liu, S.; Liu, X.; Luo, E. Metal ions: The unfading stars of bone regeneration—From bone metabolism regulation to biomaterial applications. Biomater. Sci. 2023, 11, 7268–7295. [Google Scholar] [CrossRef]
- Chen, Z.; Zhang, W.; Wang, M.; Backman, L.J.; Chen, J. Effects of zinc, magnesium, and iron ions on bone tissue engineering. ACS Biomater. Sci. Eng. 2022, 8, 2321–2335. [Google Scholar] [CrossRef] [PubMed]
- Sharifianjazi, F.; Parvin, N.; Tahriri, M. Formation of apatite nano-needles on novel gel derived SiO2-P2O5-CaO-SrO-Ag2O bioactive glasses. Ceram. Int. 2017, 43, 15214–15220. [Google Scholar] [CrossRef]
- Rau, J.V.; Antoniac, I.; Cama, G.; Komlev, V.S.; Ravaglioli, A. Bioactive Materials for Bone Tissue Engineering. BioMed Res. Int. 2016, 2016, 3741428. [Google Scholar] [CrossRef] [PubMed]
- Shearer, A.; Molinaro, M.; Montazerian, M.; Sly, J.J.; Miola, M.; Baino, F.; Mauro, J.C. The unexplored role of alkali and alkaline earth elements (ALAEs) on the structure, processing, and biological effects of bioactive glasses. Biomater. Sci. 2024, 12, 2521–2560. [Google Scholar] [CrossRef]
- Montazerian, M.; Shearer, A.; Mauro, J.C. Perspectives on the impact of crystallization in bioactive glasses and glass-ceramics. Int. J. Ceram. Eng. Sci. 2024, 6, e10194. [Google Scholar] [CrossRef]
- Chasapis, C.T.; Ntoupa, P.-S.A.; Spiliopoulou, C.A.; Stefanidou, M.E. Recent aspects of the effects of zinc on human health. Arch. Toxicol. 2020, 94, 1443–1460. [Google Scholar] [CrossRef]
- Kim, B.; Lee, W.-W. Regulatory role of zinc in immune cell signaling. Mol. Cells 2021, 44, 335–341. [Google Scholar] [CrossRef]
- Choi, S.; Hong, D.K.; Choi, B.Y.; Suh, S.W. Zinc in the brain: Friend or foe? Int. J. Mol. Sci. 2020, 21, 8941. [Google Scholar] [CrossRef]
- Fosca, M.; Streza, A.; Antoniac, I.V.; Vadalà, G.; Rau, J.V. Ion-Doped Calcium Phosphate-Based Coatings with Antibacterial Properties. J. Funct. Biomater. 2023, 14, 250. [Google Scholar] [CrossRef]
- Graziani, V.; Fosca, M.; Egorov, A.A.; Zobkov, Y.V.; Fedotov, A.Y.; Baranchikov, A.E.; Ortenzi, M.; Caminiti, R.; Komlev, V.S.; Rau, J.V. Zinc-releasing calcium phosphate cements for bone substitute materials. Ceram. Int. 2016, 42, 17310–17316. [Google Scholar] [CrossRef]
- Batool, S.A.; Ahmad, K.; Irfan, M.; Ur Rehman, M.A. Zn–Mn-Doped Mesoporous Bioactive Glass Nanoparticle-Loaded Zein Coatings for Bioactive and Antibacterial Orthopedic Implants. J. Funct. Biomater. 2022, 13, 97. [Google Scholar] [CrossRef] [PubMed]
- dos Santos, V.R.; Campos, T.M.B.; Anselmi, C.; Thim, G.P.; Bottino, M.C.; Borges, A.L.S.; de Sousa Trichês, E. Effect of Co, Cu, and Zn ions on the bioactivity and antibacterial properties of a borate bioactive glass. J. Non-Cryst. Solids 2023, 622, 122643. [Google Scholar] [CrossRef]
- Gao, Y.; Seles, M.A.; Rajan, M. Role of bioglass derivatives in tissue regeneration and repair: A review. Rev. Adv. Mater. Sci. 2023, 62, 20220318. [Google Scholar] [CrossRef]
- Ricapito, N.G.; Ghobril, C.; Zhang, H.; Grinstaff, M.W.; Putnam, D. Synthetic biomaterials from metabolically derived synthons. Chem. Rev. 2016, 116, 2664–2704. [Google Scholar] [CrossRef] [PubMed]
- Baino, F.; Fiume, E.; Barberi, J.; Kargozar, S.; Marchi, J.; Massera, J.; Verné, E. Processing methods for making porous bioactive glass-based scaffolds—A state-of-the-art review. Int. J. Appl. Ceram. Technol. 2019, 16, 1762–1796. [Google Scholar] [CrossRef]
- Özarslan, A.C.; Özel, C.; Okumuş, M.D.; Doğan, D.; Yücel, S. Development, structural and rheological characterization, and in vitro evaluation of the zinc-doped 45S5 bioactive glass-vaseline ointment for potential wound healing applications. J. Mater. Res. 2023, 38, 1557–1572. [Google Scholar] [CrossRef]
- Westhauser, F.; Wilkesmann, S.; Nawaz, Q.; Hohenbild, F.; Rehder, F.; Saur, M.; Fellenberg, J.; Moghaddam, A.; Ali, M.S.; Peukert, W. Effect of manganese, zinc, and copper on the biological and osteogenic properties of mesoporous bioactive glass nanoparticles. J. Biomed. Mater. Res. Part A 2021, 109, 1457–1467. [Google Scholar] [CrossRef]
- Azizabadi, N.; Azar, P.A.; Tehrani, M.S.; Derakhshi, P. Effect of ZnO Doping on Biological Properties of SiO2-CaO-P2O5-SrO Bioactive Nanoglasses Synthesized via the Sol–Gel Method. Silicon 2023, 15, 4835–4844. [Google Scholar] [CrossRef]
- Thanasrisuebwong, P.; Jones, J.R.; Eiamboonsert, S.; Ruangsawasdi, N.; Jirajariyavej, B.; Naruphontjirakul, P. Zinc-containing sol–gel glass nanoparticles to deliver therapeutic ions. Nanomaterials 2022, 12, 1691. [Google Scholar] [CrossRef]
- Naruphontjirakul, P.; Li, M.; Boccaccini, A.R. Strontium and Zinc Co-Doped Mesoporous Bioactive Glass Nanoparticles for Potential Use in Bone Tissue Engineering Applications. Nanomaterials 2024, 14, 575. [Google Scholar] [CrossRef]
- Turnbull, G.; Clarke, J.; Picard, F.; Riches, P.; Jia, L.; Han, F.; Li, B.; Shu, W. 3D bioactive composite scaffolds for bone tissue engineering. Bioact. Mater. 2018, 3, 278–314. [Google Scholar] [CrossRef]
- Gavinho, S.R.; Pádua, A.S.; Sá-Nogueira, I.; Silva, J.C.; Borges, J.P.; Costa, L.C.; Graça, M.P.F. Fabrication, structural and biological characterization of zinc-containing bioactive glasses and their use in membranes for guided bone regeneration. Materials 2023, 16, 956. [Google Scholar] [CrossRef] [PubMed]
- Neščáková, Z.; Zheng, K.; Liverani, L.; Nawaz, Q.; Galusková, D.; Kaňková, H.; Michálek, M.; Galusek, D.; Boccaccini, A.R. Multifunctional zinc ion doped sol-gel derived mesoporous bioactive glass nanoparticles for biomedical applications. Bioact. Mater. 2019, 4, 312–321. [Google Scholar] [CrossRef] [PubMed]
- Sun, H.; Zheng, K.; Zhou, T.; Boccaccini, A.R. Incorporation of Zinc into Binary SiO2-CaO Mesoporous Bioactive Glass Nanoparticles Enhances Anti-Inflammatory and Osteogenic Activities. Pharmaceutics 2021, 13, 2124. [Google Scholar] [CrossRef] [PubMed]
- Mutlu, N.; Kurtuldu, F.; Unalan, I.; Neščáková, Z.; Kaňková, H.; Galusková, D.; Michálek, M.; Liverani, L.; Galusek, D.; Boccaccini, A.R. Effect of Zn and Ga doping on bioactivity, degradation, and antibacterial properties of borate 1393-B3 bioactive glass. Ceram. Int. 2022, 48, 16404–16417. [Google Scholar] [CrossRef]
- Montazerian, M.; Hosseinzadeh, F.; Migneco, C.; Fook, M.V.L.; Baino, F. Bioceramic coatings on metallic implants: An overview. Ceram. Int. 2022, 48, 8987–9005. [Google Scholar] [CrossRef]
- Fiume, E.; Barberi, J.; Verné, E.; Baino, F. Bioactive Glasses: From Parent 45S5 Composition to Scaffold-Assisted Tissue-Healing Therapies. J. Funct. Biomater. 2018, 9, 24. [Google Scholar] [CrossRef]
- Niazvand, F.; Sharifianjazi, F.; Esmaeilkhanian, A.; Ahmadi, E.; Moradigharibvand, N.; Rabiee, N.; Seifalian, A.; Ghiasvand, A.; Hojjati, M. Sol-gel derived bioactive glasses containing boron and strontium: Bioactivity, biocompatibility, and antibacterial properties. J. Non-Cryst. Solids 2024, 631, 122909. [Google Scholar] [CrossRef]
- Moghanian, A.; Nasiripour, S.; Hosseini, S.M.; Hosseini, S.H.; Rashvand, A.; Ghorbanoghli, A.; Pazhouheshgar, A.; Sharifian Jazi, F. The effect of Ag substitution on physico-chemical and biological properties of sol-gel derived 60%SiO2-31%CaO-4%P2O5-5%TiO2 (mol%) quaternary bioactive glass. J. Non-Cryst. Solids 2021, 560, 120732. [Google Scholar] [CrossRef]
- Bazli, L.; Eftekhari Yekta, B.; Khavandi, A. Preparation and characterization of Sn-containing glasses for brachytherapy applications. Trans. Indian Ceram. Soc. 2017, 76, 242–246. [Google Scholar] [CrossRef]
- Ylänen, H. Bioactive Glasses: Materials, Properties and Applications; Woodhead Publishing: Sawston, UK, 2017. [Google Scholar]
- Boccaccini, A.R.; Brauer, D.S.; Hupa, L. Bioactive Glasses: Fundamentals, Technology and Applications; Royal Society of Chemistry: London, UK, 2016. [Google Scholar]
- Dahiya, M.S.; Tomer, V.K.; Duhan, S. Bioactive glass/glass ceramics for dental applications. In Applications of Nanocomposite Materials in Dentistry; Asiri, A.M., Inamuddin, Mohammad, A., Eds.; Woodhead Publishing: Sawston, UK, 2019; pp. 1–25. [Google Scholar]
- Sharifi Sedeh, E.; Mirdamadi, S.; Sharifianjazi, F.; Tahriri, M. Synthesis and evaluation of mechanical and biological properties of scaffold prepared from Ti and Mg with different volume percent. Synth. React. Inorg. Met.-Org. Nano-Met. Chem. 2015, 45, 1087–1091. [Google Scholar] [CrossRef]
- Azad Alam, M.; Asoushe, M.H.; Pourhakkak, P.; Gritsch, L.; Alipour, A.; Mohammadi, S. Preparation of bioactive polymer-based composite by different techniques and application in tissue engineering: A review. J. Compos. Compd. 2021, 3, 194–205. [Google Scholar] [CrossRef]
- Xia, W.; Chang, J. Preparation and characterization of nano-bioactive-glasses (NBG) by a quick alkali-mediated sol–gel method. Mater. Lett. 2007, 61, 3251–3253. [Google Scholar] [CrossRef]
- Tsigkou, O.; Labbaf, S.; Stevens, M.M.; Porter, A.E.; Jones, J.R. Monodispersed bioactive glass submicron particles and their effect on bone marrow and adipose tissue-derived stem cells. Adv. Healthc. Mater. 2014, 3, 115–125. [Google Scholar] [CrossRef] [PubMed]
- Bakhtiari, A.; Cheshmi, A.; Naeimi, M.; Fathabad, S.M.; Aliasghari, M.; Modarresi Chahardehi, A.; Hassani, S.; Elhami, V. Synthesis and characterization of the novel 80S bioactive glass: Bioactivity, biocompatibility, cytotoxicity. J. Compos. Compd. 2020, 2, 110–114. [Google Scholar] [CrossRef]
- Li, R.; Clark, A.; Hench, L. An investigation of bioactive glass powders by sol-gel processing. J. Appl. Biomater. 1991, 2, 231–239. [Google Scholar] [CrossRef]
- Radin, S.; El-Bassyouni, G.; Vresilovic, E.J.; Schepers, E.; Ducheyne, P. In vivo tissue response to resorbable silica xerogels as controlled-release materials. Biomaterials 2005, 26, 1043–1052. [Google Scholar] [CrossRef]
- Olmo, N.; Martín, A.I.; Salinas, A.J.; Turnay, J.; Vallet-Regí, M.a.; Lizarbe, M.A. Bioactive sol–gel glasses with and without a hydroxycarbonate apatite layer as substrates for osteoblast cell adhesion and proliferation. Biomaterials 2003, 24, 3383–3393. [Google Scholar] [CrossRef]
- Montazerian, M.; Schneider, J.F.; Yekta, B.E.; Marghussian, V.K.; Rodrigues, A.M.; Zanotto, E.D. Sol–gel synthesis, structure, sintering and properties of bioactive and inert nano-apatite–zirconia glass–ceramics. Ceram. Int. 2015, 41, 11024–11045. [Google Scholar] [CrossRef]
- Brinker, C.J.; Scherer, G.W. Sol-gel Science: The Physics and Chemistry of Sol-Gel Processing; Academic Press: Cambridge, MA, USA, 2013. [Google Scholar]
- Hench, L.L.; West, J.K. The sol-gel process. Chem. Rev. 1990, 90, 33–72. [Google Scholar] [CrossRef]
- Vichery, C.; Nedelec, J.-M. Bioactive glass nanoparticles: From synthesis to materials design for biomedical applications. Materials 2016, 9, 288. [Google Scholar] [CrossRef]
- Lukowiak, A.; Lao, J.; Lacroix, J.; Nedelec, J.-M. Bioactive glass nanoparticles obtained through sol–gel chemistry. Chem. Commun. 2013, 49, 6620–6622. [Google Scholar] [CrossRef] [PubMed]
- Jazi, F.S.; Parvin, N.; Tahriri, M.; Alizadeh, M.; Abedini, S.; Alizadeh, M. The Relationship Between the Synthesis and Morphology of SnO2-Ag2O Nanocomposite. Synth. React. Inorg. Met.-Org. Nano-Met. Chem. 2014, 44, 759–764. [Google Scholar] [CrossRef]
- Bazli, L.; Siavashi, M.; Shiravi, A. A review of carbon nanotube/TiO2 composite prepared via sol-gel method. J. Compos. Compd. 2019, 1, 1–9. [Google Scholar] [CrossRef]
- Nasr Azadani, R.; Sabbagh, M.; Salehi, H.; Cheshmi, A.; Raza, A.; Kumari, B.; Erabi, G. Sol-gel: Uncomplicated, routine and affordable synthesis procedure for utilization of composites in drug delivery: Review. J. Compos. Compd. 2021, 3, 57–70. [Google Scholar] [CrossRef]
- Deng, Z.; Lin, B.; Jiang, Z.; Huang, W.; Li, J.; Zeng, X.; Wang, H.; Wang, D.; Zhang, Y. Hypoxia-mimicking cobalt-doped borosilicate bioactive glass scaffolds with enhanced angiogenic and osteogenic capacity for bone regeneration. Int. J. Biol. Sci. 2019, 15, 1113. [Google Scholar] [CrossRef]
- Kaur, G.; Pickrell, G.; Kimsawatde, G.; Homa, D.; Allbee, H.; Sriranganathan, N. Synthesis, cytotoxicity and hydroxyapatite formation in 27-Tris-SBF for sol-gel based CaO-P2O5-SiO2-B2O3-ZnO bioactive glasses. Sci. Rep. 2014, 4, 4392. [Google Scholar] [CrossRef]
- Schatkoski, V.M.; Larissa do Amaral Montanheiro, T.; Canuto de Menezes, B.R.; Pereira, R.M.; Rodrigues, K.F.; Ribas, R.G.; Morais da Silva, D.; Thim, G.P. Current advances concerning the most cited metal ions doped bioceramics and silicate-based bioactive glasses for bone tissue engineering. Ceram. Int. 2021, 47, 2999–3012. [Google Scholar] [CrossRef]
- Mehrabi, T.; Mesgar, A.S.; Mohammadi, Z. Bioactive Glasses: A Promising Therapeutic Ion Release Strategy for Enhancing Wound Healing. ACS Biomater. Sci. Eng. 2020, 6, 5399–5430. [Google Scholar] [CrossRef]
- Goudarzi, Z.; Ijadi, A.; Bakhtiari, A.; Eskandarinezhad, S.; Azizabadi, N.; Asgari Jazi, M. Sr-doped bioactive glasses for biological applications. J. Compos. Compd. 2020, 2, 105–109. [Google Scholar] [CrossRef]
- Cacciotti, I. Bivalent cationic ions doped bioactive glasses: The influence of magnesium, zinc, strontium and copper on the physical and biological properties. J. Mater. Sci. 2017, 52, 8812–8831. [Google Scholar] [CrossRef]
- Gao, P.; Xue, Z.; Liu, G.; Zhang, J.; Zhang, M. Effects of Zn on the glass forming ability and mechanical properties of MgLi-based bulk metallic glasses. J. Non-Cryst. Solids 2012, 358, 8–13. [Google Scholar] [CrossRef]
- Karbasi, M.; Saidi, A.; Aryanpour, G. Study of structure and usage of mechanically alloyed nanocrystalline Ti–Cu–Zn powders in powder metallurgy. Powder Metall. 2008, 51, 250–253. [Google Scholar] [CrossRef]
- Rocton, N.; Oudadesse, H.; Lefeuvre, B. Comparison of Zn and Sr effects on thermal properties and on the excess entropy of doped glasses for use in the biomedical field. Thermochim. Acta 2018, 668, 58–64. [Google Scholar] [CrossRef]
- Wers, E.; Oudadesse, H. Thermal behaviour and excess entropy of bioactive glasses and Zn-doped glasses. J. Therm. Anal. Calorim. 2014, 115, 2137–2144. [Google Scholar] [CrossRef]
- Mohan Babu, M.; Syam Prasad, P.; Hima Bindu, S.; Prasad, A.; Venkateswara Rao, P.; Putenpurayil Govindan, N.; Veeraiah, N.; Özcan, M. Investigations on Physico-Mechanical and Spectral Studies of Zn2+ Doped P2O5-Based Bioglass System. J. Compos. Sci. 2020, 4, 129. [Google Scholar] [CrossRef]
- Hoppe, A.; Güldal, N.S.; Boccaccini, A.R. A review of the biological response to ionic dissolution products from bioactive glasses and glass-ceramics. Biomaterials 2011, 32, 2757–2774. [Google Scholar] [CrossRef]
- Chen, Y.-H.; Tseng, S.-P.; Wu, S.-M.; Shih, C.-J. Structure-dependence of anti-methicillin-resistant staphylococcus aureus (MRSA) activity on ZnO-containing bioglass. J. Alloys Compd. 2020, 848, 156487. [Google Scholar] [CrossRef]
- Malavasi, G.; Lusvardi, G.; Pedone, A.; Menziani, M.C.; Dappiaggi, M.; Gualtieri, A.; Menabue, L. Crystallization Kinetics of Bioactive Glasses in the ZnO–Na2O–CaO–SiO2 System. J. Phys. Chem. A 2007, 111, 8401–8408. [Google Scholar] [CrossRef]
- Linati, L.; Lusvardi, G.; Malavasi, G.; Menabue, L.; Menziani, M.C.; Mustarelli, P.; Segre, U. Qualitative and Quantitative Structure–Property Relationships Analysis of Multicomponent Potential Bioglasses. J. Phys. Chem. B 2005, 109, 4989–4998. [Google Scholar] [CrossRef]
- Lusvardi, G.; Malavasi, G.; Menabue, L.; Menziani, M.C. Synthesis, characterization, and molecular dynamics simulation of Na2O–CaO–SiO2–ZnO glasses. J. Phys. Chem. B 2002, 106, 9753–9760. [Google Scholar] [CrossRef]
- Pedone, A.; Menziani, M.C. Computational modeling of silicate glasses: A quantitative structure-property relationship perspective. In Molecular Dynamics Simulations of Disordered Materials: From Network Glasses to Phase-Change Memory Alloys; Springer: Cham, Switzerland, 2015; pp. 113–135. [Google Scholar] [CrossRef]
- Montazerian, M.; Zanotto, E.D.; Mauro, J.C. Model-driven design of bioactive glasses: From molecular dynamics through machine learning. Int. Mater. Rev. 2020, 65, 297–321. [Google Scholar] [CrossRef]
- Xiang, Y.; Du, J.; Skinner, L.B.; Benmore, C.J.; Wren, A.W.; Boyd, D.J.; Towler, M.R. Structure and diffusion of ZnO–SrO–CaO–Na2O–SiO2 bioactive glasses: A combined high energy X-ray diffraction and molecular dynamics simulations study. RSC Adv. 2013, 3, 5966–5978. [Google Scholar] [CrossRef]
- Oki, A.; Parveen, B.; Hossain, S.; Adeniji, S.; Donahue, H. Preparation and in vitro bioactivity of zinc containing sol-gel–derived bioglass materials. J. Biomed. Mater. Res. Part A Off. J. Soc. Biomater. Jpn. Soc. Biomater. Aust. Soc. Biomater. Korean Soc. Biomater. 2004, 69, 216–221. [Google Scholar] [CrossRef]
- Li, P.; Zhang, F. The electrochemistry of a glass surface and its application to bioactive glass in solution. J. Non-Cryst. Solids 1990, 119, 112–118. [Google Scholar] [CrossRef]
- Aina, V.; Perardi, A.; Bergandi, L.; Malavasi, G.; Menabue, L.; Morterra, C.; Ghigo, D. Cytotoxicity of zinc-containing bioactive glasses in contact with human osteoblasts. Chem.-Biol. Interact. 2007, 167, 207–218. [Google Scholar] [CrossRef]
- Fandzloch, M.; Bodylska, W.; Barszcz, B.; Trzcińska-Wencel, J.; Roszek, K.; Golińska, P.; Lukowiak, A. Effect of ZnO on sol–gel glass properties toward (bio)application. Polyhedron 2022, 223, 115952. [Google Scholar] [CrossRef]
- Shahrbabak, M.S.N.; Sharifianjazi, F.; Rahban, D.; Salimi, A. A Comparative Investigation on Bioactivity and Antibacterial Properties of Sol-Gel Derived 58S Bioactive Glass Substituted by Ag and Zn. Silicon 2019, 11, 2741–2751. [Google Scholar] [CrossRef]
- Sergi, R.; Bellucci, D.; Salvatori, R.; Maisetta, G.; Batoni, G.; Cannillo, V. Zinc containing bioactive glasses with ultra-high crystallization temperature, good biological performance and antibacterial effects. Mater. Sci. Eng. C 2019, 104, 109910. [Google Scholar] [CrossRef] [PubMed]
- Taye, M.B. Biomedical applications of ion-doped bioactive glass: A review. Appl. Nanosci. 2022, 12, 3797–3812. [Google Scholar] [CrossRef]
- Fong, L.; Tan, K.; Tran, C.; Cool, J.; Scherer, M.A.; Elovaris, R.; Coyle, P.; Foster, B.K.; Rofe, A.M.; Xian, C.J. Interaction of dietary zinc and intracellular binding protein metallothionein in postnatal bone growth. Bone 2009, 44, 1151–1162. [Google Scholar] [CrossRef]
- Lang, C.; Murgia, C.; Leong, M.; Tan, L.-W.; Perozzi, G.; Knight, D.; Ruffin, R.; Zalewski, P. Anti-inflammatory effects of zinc and alterations in zinc transporter mRNA in mouse models of allergic inflammation. Am. J. Physiol.-Lung Cell. Mol. Physiol. 2007, 292, L577–L584. [Google Scholar] [CrossRef] [PubMed]
- Pasqualini, R.; Barbas, C.F., III; Arap, W. Vessel maneuvers: Zinc fingers promote angiogenesis. Nat. Med. 2002, 8, 1353–1354. [Google Scholar] [CrossRef] [PubMed]
- Cho, Y.-H.; Lee, S.-J.; Lee, J.Y.; Kim, S.W.; Lee, C.B.; Lee, W.Y.; Yoon, M.S. Antibacterial effect of intraprostatic zinc injection in a rat model of chronic bacterial prostatitis. Int. J. Antimicrob. Agents 2002, 19, 576–582. [Google Scholar] [CrossRef] [PubMed]
- Phan, T.N.; Buckner, T.; Sheng, J.; Baldeck, J.; Marquis, R. Physiologic actions of zinc related to inhibition of acid and alkali production by oral streptococci in suspensions and biofilms. Oral Microbiol. Immunol. 2004, 19, 31–38. [Google Scholar] [CrossRef]
- Balasubramanian, P.; Strobel, L.A.; Kneser, U.; Boccaccini, A.R. Zinc-containing bioactive glasses for bone regeneration, dental and orthopedic applications. Biomed. Glas. 2015, 1, 51–69. [Google Scholar] [CrossRef]
- Salinas, A.J.; Vallet-Regí, M. Glasses in bone regeneration: A multiscale issue. J. Non-Cryst. Solids 2016, 432, 9–14. [Google Scholar] [CrossRef]
- Balamurugan, A.; Balossier, G.; Kannan, S.; Michel, J.; Rebelo, A.H.; Ferreira, J.M. Development and in vitro characterization of sol–gel derived CaO–P2O5–SiO2–ZnO bioglass. Acta Biomater. 2007, 3, 255–262. [Google Scholar] [CrossRef]
- Bini, M.; Grandi, S.; Capsoni, D.; Mustarelli, P.; Saino, E.; Visai, L. SiO2–P2O5–CaO glasses and glass-ceramics with and without ZnO: Relationships among composition, microstructure, and bioactivity. J. Phys. Chem. C 2009, 113, 8821–8828. [Google Scholar] [CrossRef]
- Zhao, R.; Shi, L.; Gu, L.; Qin, X.; Song, Z.; Fan, X.; Zhao, P.; Li, C.; Zheng, H.; Li, Z. Evaluation of bioactive glass scaffolds incorporating SrO or ZnO for bone repair: In vitro bioactivity and antibacterial activity. J. Appl. Biomater. Funct. Mater. 2021, 19, 22808000211040910. [Google Scholar] [CrossRef]
- Westhauser, F.; Decker, S.; Nawaz, Q.; Rehder, F.; Wilkesmann, S.; Moghaddam, A.; Kunisch, E.; Boccaccini, A.R. Impact of zinc-or copper-doped mesoporous bioactive glass nanoparticles on the osteogenic differentiation and matrix formation of mesenchymal stromal cells. Materials 2021, 14, 1864. [Google Scholar] [CrossRef] [PubMed]
- Oh, S.-A.; Kim, S.-H.; Won, J.-E.; Kim, J.-J.; Shin, U.S.; Kim, H.-W. Effects on growth and osteogenic differentiation of mesenchymal stem cells by the zinc-added sol-gel bioactive glass granules. J. Tissue Eng. 2010, 1, 475260. [Google Scholar] [CrossRef] [PubMed]
- Yamaguchi, M.; Yamaguchi, R. Action of zinc on bone metabolism in rats: Increases in alkaline phosphatase activity and DNA content. Biochem. Pharmacol. 1986, 35, 773–777. [Google Scholar] [CrossRef]
- Huang, M.; Hill, R.G.; Rawlinson, S.C. Zinc bioglasses regulate mineralization in human dental pulp stem cells. Dent. Mater. 2017, 33, 543–552. [Google Scholar] [CrossRef]
- Saino, E.; Grandi, S.; Quartarone, E.; Maliardi, V.; Galli, D.; Bloise, N.; Fassina, L.; De Angelis, M.G.C.; Mustarelli, P.; Imbriani, M. In vitro calcified matrix deposition by human osteoblasts onto a zinc-containing bioactive glass. Eur. Cell Mater. 2011, 21, 59–72. [Google Scholar] [CrossRef]
- Zheng, K.; Lu, M.; Rutkowski, B.; Dai, X.; Yang, Y.; Taccardi, N.; Stachewicz, U.; Czyrska-Filemonowicz, A.; Hüser, N.; Boccaccini, A.R. ZnO quantum dots modified bioactive glass nanoparticles with pH-sensitive release of Zn ions, fluorescence, antibacterial and osteogenic properties. J. Mater. Chem. B 2016, 4, 7936–7949. [Google Scholar] [CrossRef] [PubMed]
- O’Connor, J.P.; Kanjilal, D.; Teitelbaum, M.; Lin, S.S.; Cottrell, J.A. Zinc as a Therapeutic Agent in Bone Regeneration. Materials 2020, 13, 2211. [Google Scholar] [CrossRef]
- Coleman, J.E. Zinc proteins: Enzymes, storage proteins, transcription factors, and replication proteins. Annu. Rev. Biochem. 1992, 61, 897–946. [Google Scholar] [CrossRef]
- Yu, H.; Peng, J.; Xu, Y.; Chang, J.; Li, H. Bioglass Activated Skin Tissue Engineering Constructs for Wound Healing. ACS Appl. Mater. Interfaces 2016, 8, 703–715. [Google Scholar] [CrossRef]
- Li, J.; Zhang, Y.P.; Kirsner, R.S. Angiogenesis in wound repair: Angiogenic growth factors and the extracellular matrix. Microsc. Res. Tech. 2003, 60, 107–114. [Google Scholar] [CrossRef]
- Zhang, J.; Park, Y.-D.; Bae, W.-J.; El-Fiqi, A.; Shin, S.-H.; Lee, E.-J.; Kim, H.-W.; Kim, E.-C. Effects of bioactive cements incorporating zinc-bioglass nanoparticles on odontogenic and angiogenic potential of human dental pulp cells. J. Biomater. Appl. 2015, 29, 954–964. [Google Scholar] [CrossRef]
- Seo, H.-J.; Cho, Y.-E.; Kim, T.; Shin, H.-I.; Kwun, I.-S. Zinc may increase bone formation through stimulating cell proliferation, alkaline phosphatase activity and collagen synthesis in osteoblastic MC3T3-E1 cells. Nutr. Res. Pract. 2010, 4, 356–361. [Google Scholar] [CrossRef]
- Prasad, A.S. Zinc is an Antioxidant and Anti-Inflammatory Agent: Its Role in Human Health. Front. Nutr. 2014, 1, 14. [Google Scholar] [CrossRef]
- Chen, Y.; Cai, J.; Liu, D.; Liu, S.; Lei, D.; Zheng, L.; Wei, Q.; Gao, M. Zinc-based metal organic framework with antibacterial and anti-inflammatory properties for promoting wound healing. Regen. Biomater. 2022, 9, rbac019. [Google Scholar] [CrossRef]
- Vasconcelos, D.P.; Águas, A.P.; Barbosa, M.A.; Pelegrín, P.; Barbosa, J.N. The inflammasome in host response to biomaterials: Bridging inflammation and tissue regeneration. Acta Biomater. 2019, 83, 1–12. [Google Scholar] [CrossRef]
- Bosetti, M.; Hench, L.; Cannas, M. Interaction of bioactive glasses with peritoneal macrophages and monocytes in vitro. J. Biomed. Mater. Res. 2002, 60, 79–85. [Google Scholar] [CrossRef]
- Dierichs, L.; Kloubert, V.; Rink, L. Cellular zinc homeostasis modulates polarization of THP-1-derived macrophages. Eur. J. Nutr. 2018, 57, 2161–2169. [Google Scholar] [CrossRef]
- Liu, W.; Li, J.; Cheng, M.; Wang, Q.; Yeung, K.W.; Chu, P.K.; Zhang, X. Zinc-modified sulfonated polyetheretherketone surface with immunomodulatory function for guiding cell fate and bone regeneration. Adv. Sci. 2018, 5, 1800749. [Google Scholar] [CrossRef] [PubMed]
- Varmette, E.A.; Nowalk, J.R.; Flick, L.M.; Hall, M.M. Abrogation of the inflammatory response in LPS-stimulated RAW 264.7 murine macrophages by Zn- and Cu-doped bioactive sol–gel glasses. J. Biomed. Mater. Res. Part A 2009, 90A, 317–325. [Google Scholar] [CrossRef]
- Haimi, S.; Gorianc, G.; Moimas, L.; Lindroos, B.; Huhtala, H.; Räty, S.; Kuokkanen, H.; Sándor, G.K.; Schmid, C.; Miettinen, S. Characterization of zinc-releasing three-dimensional bioactive glass scaffolds and their effect on human adipose stem cell proliferation and osteogenic differentiation. Acta Biomater. 2009, 5, 3122–3131. [Google Scholar] [CrossRef]
- Aina, V.; Malavasi, G.; Pla, A.F.; Munaron, L.; Morterra, C. Zinc-containing bioactive glasses: Surface reactivity and behaviour towards endothelial cells. Acta Biomater. 2009, 5, 1211–1222. [Google Scholar] [CrossRef] [PubMed]
- Sánchez-Salcedo, S.; Shruti, S.; Salinas, A.J.; Malavasi, G.; Menabue, L.; Vallet-Regi, M. In vitro antibacterial capacity and cytocompatibility of SiO2–CaO–P2O5 meso-macroporous glass scaffolds enriched with ZnO. J. Mater. Chem. B 2014, 2, 4836–4847. [Google Scholar] [CrossRef]
- Pérez, R.; Sanchez-Salcedo, S.; Lozano, D.; Heras, C.; Esbrit, P.; Vallet-Regí, M.; Salinas, A.J. Osteogenic effect of ZnO-mesoporous glasses loaded with osteostatin. Nanomaterials 2018, 8, 592. [Google Scholar] [CrossRef] [PubMed]
- Baino, F.; Hamzehlou, S.; Kargozar, S. Bioactive Glasses: Where Are We and Where Are We Going? J. Funct. Biomater. 2018, 9, 25. [Google Scholar] [CrossRef] [PubMed]
- Hench, L.L. The story of Bioglass®. J. Mater. Sci. Mater. Med. 2006, 17, 967–978. [Google Scholar] [CrossRef] [PubMed]
- Huang, T.; Yan, G.; Guan, M. Zinc Homeostasis in Bone: Zinc Transporters and Bone Diseases. Int. J. Mol. Sci. 2020, 21, 1236. [Google Scholar] [CrossRef]
- Amin, N.; Clark, C.C.T.; Taghizadeh, M.; Djafarnejad, S. Zinc supplements and bone health: The role of the RANKL-RANK axis as a therapeutic target. J. Trace Elem. Med. Biol. 2020, 57, 126417. [Google Scholar] [CrossRef]
- Elahpour, N.; Niesner, I.; Bossard, C.; Abdellaoui, N.; Montouillout, V.; Fayon, F.; Taviot-Guého, C.; Frankenbach, T.; Crispin, A.; Khosravani, P.; et al. Zinc-Doped Bioactive Glass/Polycaprolactone Hybrid Scaffolds Manufactured by Direct and Indirect 3D Printing Methods for Bone Regeneration. Cells 2023, 12, 1759. [Google Scholar] [CrossRef]
- Wang, X.; Li, X.; Ito, A.; Sogo, Y. Synthesis and characterization of hierarchically macroporous and mesoporous CaO–MO–SiO2–P2O5 (M = Mg, Zn, Sr) bioactive glass scaffolds. Acta Biomater. 2011, 7, 3638–3644. [Google Scholar] [CrossRef]
- Shuai, C.; Zhou, J.; Gao, D.; Gao, C.; Feng, P.; Peng, S. Functionalization of calcium sulfate/bioglass scaffolds with zinc oxide whisker. Molecules 2016, 21, 378. [Google Scholar] [CrossRef]
- Bejarano, J.; Caviedes, P.; Palza, H. Sol–gel synthesis and in vitro bioactivity of copper and zinc-doped silicate bioactive glasses and glass-ceramics. Biomed. Mater. 2015, 10, 025001. [Google Scholar] [CrossRef] [PubMed]
- Bejarano, J.; Boccaccini, A.R.; Covarrubias, C.; Palza, H. Effect of Cu- and Zn-Doped Bioactive Glasses on the In Vitro Bioactivity, Mechanical and Degradation Behavior of Biodegradable PDLLA Scaffolds. Materials 2020, 13, 2908. [Google Scholar] [CrossRef] [PubMed]
- Krell, E.S.; Ippolito, J.A.; Montemurro, N.J.; Lim, P.H.; Vincent, R.A.; Hreha, J.; Cottrell, J.; Sudah, S.Y.; Muñoz, M.F.; Pacific, K.P. Local zinc chloride release from a calcium sulfate carrier enhances fracture healing. J. Orthop. Trauma 2017, 31, 168–174. [Google Scholar] [CrossRef] [PubMed]
- Imai, K.; Nishikawa, T.; Tanaka, A.; Suese, K.; Takashima, H.; Takeda, S. In vitro new capillary formation with eight metal ions of dental biomaterials. J. Oral Tissue Eng. 2010, 8, 74–79. [Google Scholar] [CrossRef]
- Wang, H.; Zhao, S.; Xiao, W.; Cui, X.; Huang, W.; Rahaman, M.N.; Zhang, C.; Wang, D. Three-dimensional zinc incorporated borosilicate bioactive glass scaffolds for rodent critical-sized calvarial defects repair and regeneration. Colloids Surf. B Biointerfaces 2015, 130, 149–156. [Google Scholar] [CrossRef]
- Rajzer, I.; Dziadek, M.; Kurowska, A.; Cholewa-Kowalska, K.; Ziąbka, M.; Menaszek, E.; Douglas, T.E.L. Electrospun polycaprolactone membranes with Zn-doped bioglass for nasal tissues treatment. J. Mater. Sci. Mater. Med. 2019, 30, 80. [Google Scholar] [CrossRef]
- Kim, D.; Shim, Y.S.; An, S.Y.; Lee, M.J. Role of Zinc-Doped Bioactive Glass Encapsulated with Microspherical Gelatin in Localized Supplementation for Tissue Regeneration: A Contemporary Review. Molecules 2021, 26, 1823. [Google Scholar] [CrossRef] [PubMed]
- Montazerian, M.; Baino, F.; Fiume, E.; Migneco, C.; Alaghmandfard, A.; Sedighi, O.; DeCeanne, A.V.; Wilkinson, C.J.; Mauro, J.C. Glass-ceramics in dentistry: Fundamentals, technologies, experimental techniques, applications, and open issues. Prog. Mater. Sci. 2023, 132, 101023. [Google Scholar] [CrossRef]
- Sharifi, E.; Yousefiasl, S.; Laderian, N.; Rabiee, N.; Makvandi, P.; Pourmotabed, S.; Ashrafizadeh, M.; Familsattarian, F.; Fang, W. Cell-loaded genipin cross-linked collagen/gelatin skin substitute adorned with zinc-doped bioactive glass-ceramic for cutaneous wound regeneration. Int. J. Biol. Macromol. 2023, 251, 125898. [Google Scholar] [CrossRef]
- Paramita, P.; Ramachandran, M.; Narashiman, S.; Nagarajan, S.; Sukumar, D.K.; Chung, T.-W.; Ambigapathi, M. Sol–gel based synthesis and biological properties of zinc integrated nano bioglass ceramics for bone tissue regeneration. J. Mater. Sci. Mater. Med. 2021, 32, 5. [Google Scholar] [CrossRef]
- Pal Singh Sidhu, V.; Borges, R.; Yusuf, M.; Mahmoudi, S.; Fallah Ghorbani, S.; Hosseinikia, M.; Salahshour, P.; Sadeghi, F.; Arefian, M. A comprehensive review of bioactive glass: Synthesis, ion substitution, application, challenges, and future perspectives. J. Compos. Compd. 2021, 3, 247–261. [Google Scholar] [CrossRef]
- Baltaci, A.K.; Yuce, K.; Mogulkoc, R. Zinc Metabolism and Metallothioneins. Biol Trace Elem Res 2018, 183, 22–31. [Google Scholar] [CrossRef] [PubMed]
- Aitken, J. Factors affecting the distribution of zinc in the human skeleton. Calcif. Tissue Res. 1976, 20, 23–30. [Google Scholar] [CrossRef] [PubMed]
- Qiao, Y.; Zhang, W.; Tian, P.; Meng, F.; Zhu, H.; Jiang, X.; Liu, X.; Chu, P.K. Stimulation of bone growth following zinc incorporation into biomaterials. Biomaterials 2014, 35, 6882–6897. [Google Scholar] [CrossRef]
- Chen, X.; Brauer, D.; Karpukhina, N.; Waite, R.; Barry, M.; McKay, I.; Hill, R. ‘Smart’acid-degradable zinc-releasing silicate glasses. Mater. Lett. 2014, 126, 278–280. [Google Scholar] [CrossRef]
- Lotfibakhshaiesh, N.; Brauer, D.S.; Hill, R.G. Bioactive glass engineered coatings for Ti6Al4V alloys: Influence of strontium substitution for calcium on sintering behaviour. J. Non-Cryst. Solids 2010, 356, 2583–2590. [Google Scholar] [CrossRef]
- Lansdown, A.B.; Mirastschijski, U.; Stubbs, N.; Scanlon, E.; Ågren, M.S. Zinc in wound healing: Theoretical, experimental, and clinical aspects. Wound Repair Regen. 2007, 15, 2–16. [Google Scholar] [CrossRef]
- Soundrapandian, C.; Bharati, S.; Basu, D.; Datta, S. Studies on novel bioactive glasses and bioactive glass–nano-HAp composites suitable for coating on metallic implants. Ceram. Int. 2011, 37, 759–769. [Google Scholar] [CrossRef]
- Chen, Q.; Zhao, X.; Lai, W.; Li, Z.; You, D.; Yu, Z.; Li, W.; Wang, X. Surface functionalization of 3D printed Ti scaffold with Zn-containing mesoporous bioactive glass. Surf. Coat. Technol. 2022, 435, 128236. [Google Scholar] [CrossRef]
- Rolvien, T.; Barbeck, M.; Wenisch, S.; Amling, M.; Krause, M. Cellular mechanisms responsible for success and failure of bone substitute materials. Int. J. Mol. Sci. 2018, 19, 2893. [Google Scholar] [CrossRef]
- Zhang, K.; Van Le, Q. Bioactive glass coated zirconia for dental implants: A review. J. Compos. Compd. 2020, 2, 10–17. [Google Scholar] [CrossRef]
- Kumar, P.; Vinitha, B.; Fathima, G. Bone grafts in dentistry. J. Pharm. Bioallied Sci. 2013, 5, S125–S127. [Google Scholar] [CrossRef]
- Boyd, D.; Carroll, G.; Towler, M.R.; Freeman, C.; Farthing, P.; Brook, I. Preliminary investigation of novel bone graft substitutes based on strontium–calcium–zinc–silicate glasses. J. Mater. Sci. Mater. Med. 2009, 20, 413–420. [Google Scholar] [CrossRef]
- Valm, A.M. The Structure of Dental Plaque Microbial Communities in the Transition from Health to Dental Caries and Periodontal Disease. J. Mol. Biol. 2019, 431, 2957–2969. [Google Scholar] [CrossRef]
- Uskoković, V.; Abuna, G.; Ferreira, P.; Wu, V.M.; Gower, L.; Pires-de-Souza, F.C.P.; Murata, R.M.; Sinhoreti, M.A.C.; Geraldeli, S. Synthesis and characterization of nanoparticulate niobium- and zinc-doped bioglass-ceramic/chitosan hybrids for dental applications. J. Sol-Gel Sci. Technol. 2021, 97, 245–258. [Google Scholar] [CrossRef]
- Kamitakahara, M.; Ohtsuki, C.; Inada, H.; Tanihara, M.; Miyazaki, T. Effect of ZnO addition on bioactive CaO–SiO2–P2O5–CaF2 glass–ceramics containing apatite and wollastonite. Acta Biomater. 2006, 2, 467–471. [Google Scholar] [CrossRef]
- El-Kady, A.M.; Ali, A.F. Fabrication and characterization of ZnO modified bioactive glass nanoparticles. Ceram. Int. 2012, 38, 1195–1204. [Google Scholar] [CrossRef]
- Looney, M.; O’Shea, H.; Boyd, D. Preliminary evaluation of therapeutic ion release from Sr-doped zinc-silicate glass ceramics. J. Biomater. Appl. 2013, 27, 511–524. [Google Scholar] [CrossRef]
- Soundrapandian, C.; Mahato, A.; Kundu, B.; Datta, S.; Sa, B.; Basu, D. Development and effect of different bioactive silicate glass scaffolds: In vitro evaluation for use as a bone drug delivery system. J. Mech. Behav. Biomed. Mater. 2014, 40, 1–12. [Google Scholar] [CrossRef]
- Anand, V.; Singh, K.J.; Kaur, K. Evaluation of zinc and magnesium doped 45S5 mesoporous bioactive glass system for the growth of hydroxyl apatite layer. J. Non-Cryst. Solids 2014, 406, 88–94. [Google Scholar] [CrossRef]
- Anand, V.; Singh, K.J.; Kaur, K.; Kaur, H.; Arora, D.S. B2O3–MgO–SiO2–Na2O–CaO–P2O5–ZnO bioactive system for bone regeneration applications. Ceram. Int. 2016, 42, 3638–3651. [Google Scholar] [CrossRef]
- Heras, C.; Jiménez-Holguín, J.; Doadrio, A.L.; Vallet-Regí, M.; Sánchez-Salcedo, S.; Salinas, A.J. Multifunctional antibiotic- and zinc-containing mesoporous bioactive glass scaffolds to fight bone infection. Acta Biomater. 2020, 114, 395–406. [Google Scholar] [CrossRef]
- Vi, V.T.; Vuong, B.X. Dissolution and Bio-compatibility of ZnO Doped Bioactive Glasses after In Vitro Experiment. Asian J. Appl. Sci. Technol. (AJAST) 2022, 6, 186–193. [Google Scholar] [CrossRef]
- Goudarzi, Z.; Parvin, N.; Sharifianjazi, F. Formation of hydroxyapatite on surface of SiO2–P2O5–CaO–SrO–ZnO bioactive glass synthesized through sol-gel route. Ceram. Int. 2019, 45, 19323–19330. [Google Scholar] [CrossRef]

| Method | Advantages | Drawbacks | Ref. |
|---|---|---|---|
| Sol-gel |
|
| [59,68,69] |
| Melt-quenching |
|
| [70,71,72,73,74] |
Disclaimer/Publisher’s Note: The statements, opinions and data contained in all publications are solely those of the individual author(s) and contributor(s) and not of MDPI and/or the editor(s). MDPI and/or the editor(s) disclaim responsibility for any injury to people or property resulting from any ideas, methods, instructions or products referred to in the content. |
© 2024 by the authors. Licensee MDPI, Basel, Switzerland. This article is an open access article distributed under the terms and conditions of the Creative Commons Attribution (CC BY) license (https://creativecommons.org/licenses/by/4.0/).
Share and Cite
Sharifianjazi, F.; Sharifianjazi, M.; Irandoost, M.; Tavamaishvili, K.; Mohabatkhah, M.; Montazerian, M. Advances in Zinc-Containing Bioactive Glasses: A Comprehensive Review. J. Funct. Biomater. 2024, 15, 258. https://doi.org/10.3390/jfb15090258
Sharifianjazi F, Sharifianjazi M, Irandoost M, Tavamaishvili K, Mohabatkhah M, Montazerian M. Advances in Zinc-Containing Bioactive Glasses: A Comprehensive Review. Journal of Functional Biomaterials. 2024; 15(9):258. https://doi.org/10.3390/jfb15090258
Chicago/Turabian StyleSharifianjazi, Fariborz, Mohammadjavad Sharifianjazi, Maryam Irandoost, Ketevan Tavamaishvili, Mehdi Mohabatkhah, and Maziar Montazerian. 2024. "Advances in Zinc-Containing Bioactive Glasses: A Comprehensive Review" Journal of Functional Biomaterials 15, no. 9: 258. https://doi.org/10.3390/jfb15090258
APA StyleSharifianjazi, F., Sharifianjazi, M., Irandoost, M., Tavamaishvili, K., Mohabatkhah, M., & Montazerian, M. (2024). Advances in Zinc-Containing Bioactive Glasses: A Comprehensive Review. Journal of Functional Biomaterials, 15(9), 258. https://doi.org/10.3390/jfb15090258








